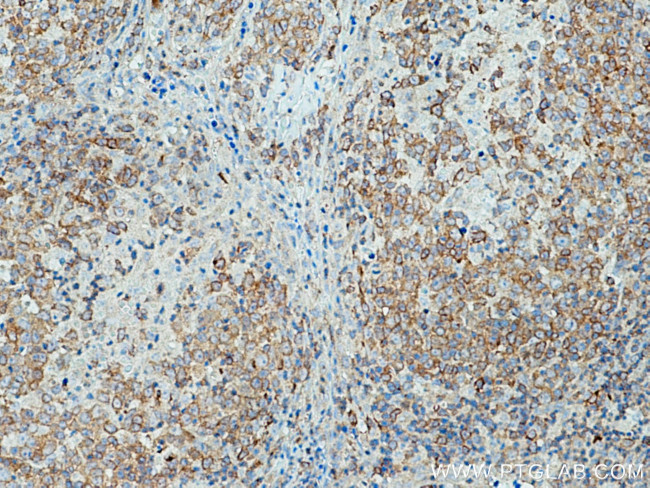
c-Cbl Antibody in Immunohistochemistry (Paraffin) (IHC (P))

Search
Proteintech
c-Cbl Polyclonal Antibody
{{$productOrderCtrl.translations['antibody.pdp.commerceCard.promotion.promotions']}}
{{$productOrderCtrl.translations['antibody.pdp.commerceCard.promotion.viewpromo']}}
{{$productOrderCtrl.translations['antibody.pdp.commerceCard.promotion.promocode']}}: {{promo.promoCode}} {{promo.promoTitle}} {{promo.promoDescription}}. {{$productOrderCtrl.translations['antibody.pdp.commerceCard.promotion.learnmore']}}
产品信息
25818-1-AP
种属反应
已发表种属
宿主/亚型
分类
类型
抗原
偶联物
形式
浓度
规格
纯化类型
保存液
内含物
保存条件
运输条件
产品详细信息
Immunogen sequence: LPPVPSSRL GDSWLPRPIP KVPVSAPSSS DPWTGRELTN RHSLPFSLPS QMEPRPDVPR LGSTFSLDTS MSMNSSPLVG PECDHPKIKP SSSANAIYSL AARPLPVPKL PPGEQCEGEE DTEYMTPSSR PLRPLDTSQS SRACDCDQQI DSCTYEAMYN IQSQAPSITE SSTFGEGNLA AAHANTGPEE SENEDDGYDV PKPPVPAVLA RRTLSDISNA SSSFGWLSLD GDPTTNVTEG SQVPERPPKP FPRRINSERK AGSCQQGSGP AASAATASPQ LSSEIENLMS QGYSYQDIQK ALVIAQNNIE MAKNILREFV SISSPAHVAT (578-906 aa encoded by BC132733)
靶标信息
Cbl proteins are a family of ubiquitin protein ligases (E3s) that negatively regulate signaling by targeting activated tyrosine kinases for degradation. Cbl- c is the most recently cloned member of the Cbl proteins and is expressed only in epithelial cells (the other Cbl proteins are ubiquitously expressed). Cbl-c, like the other mammalian Cbl proteins, can ubiquitinate the activated EGFR and target it for degradation. Through interactions with proteins containing SRC homology-2 (SH2) and SH3 domains, CBL proteins modulate downstream cell signaling.
仅用于科研。不用于诊断过程。未经明确授权不得转售。
生物信息学
蛋白别名: c-cbl; Cas-Br-M (murine) ecotropic retroviral transforming sequence; Casitas B-lineage lymphoma proto-oncogene; Cbl proto-oncogene, E3 ubiquitin protein ligase; CBL-3; CBLC; E3 ubiquitin-protein ligase CBL; fragile site, folic acid type, rare, fra(11)(q23.3); oncogene CBL2; Proto-oncogene c-Cbl; RING finger protein 55; RING-type E3 ubiquitin transferase CBL; RNF57; Signal transduction protein CBL
基因别名: 4732447J05Rik; C-CBL; CBL; Cbl-2; CBL2; FRA11B; NSLL; RNF55
UniProt ID: (Human) P22681, (Mouse) P22682
Entrez Gene ID: (Human) 867, (Mouse) 12402